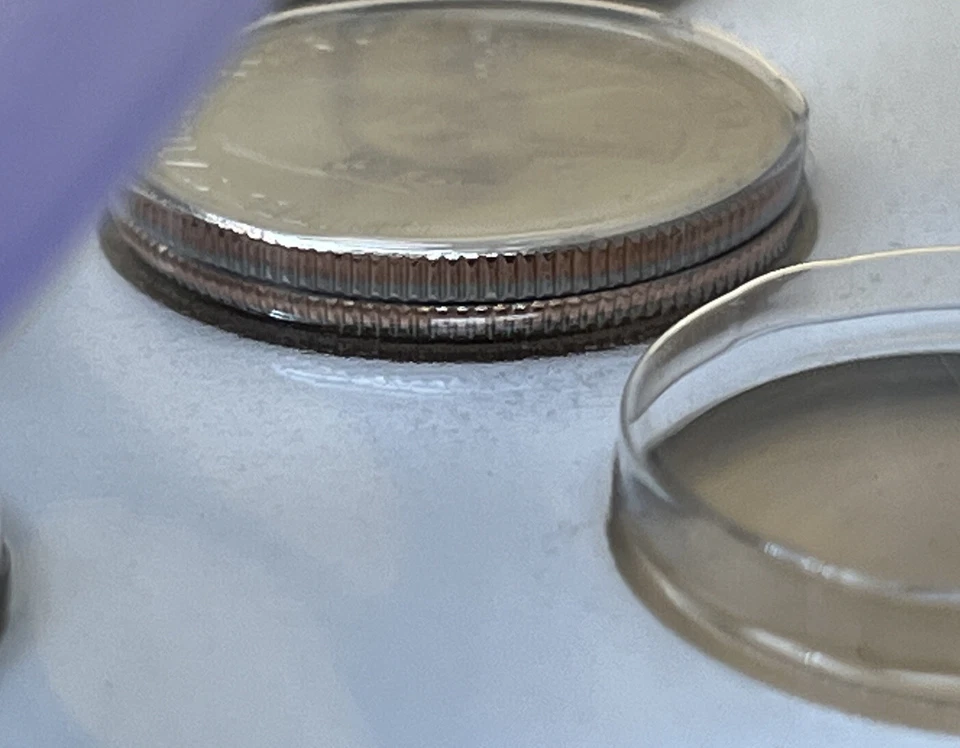
2010 Philly Mint US Sealed Pkg Unc. full set ERROR PKG RARE! 💎 2 Coins 1 Cell - Image 2 of 4

2010 Ungraded US Coin Mint Sets
Shop by category
118 results
Sort: Best Match
- RM 3,357.77Was: RM 7,461.71was - RM 7,461.71or Best OfferRM 212.24 shipping
- RM 199.09or Best OfferRM 99.79 shipping
- RM 140.81or Best OfferRM 104.90 shippingOnly 1 left!
- RM 109.91Was: RM 115.72was - RM 115.72RM 101.25 shipping
- RM 51.85RM 97.72 shipping8 bids5d 4h
- RM 12.40RM 102.28 shipping0 bids4d 6h
- RM 82.91or Best OfferRM 102.78 shipping0 bids5d 4h
- RM 33.14RM 126.92 shipping0 bids6d 7h
- RM 33.14RM 126.92 shipping0 bids6d 7h
- RM 41.44RM 126.92 shipping0 bids6d 7h
- RM 103.65or Best OfferRM 76.23 shipping
- RM 112.69or Best OfferRM 97.01 shipping
- RM 98.96or Best OfferFree international shipping
- RM 106.02Was: RM 111.57was - RM 111.57RM 101.12 shippingOnly 1 left!
- RM 107.84RM 103.69 shipping
- RM 311.08or Best OfferRM 82.33 shipping
- RM 331.82or Best OfferRM 91.87 shipping0 bids1d 4h
- RM 53.88RM 111.53 shipping0 bids3d 19h
- RM 111.86RM 76.48 shipping
- RM 116.09RM 76.61 shipping
- RM 414.77or Best OfferRM 188.31 shipping
- RM 118.21RM 64.87 shipping
- RM 118.83RM 98.30 shipping0 bids2d 2h
- RM 116.09or Best OfferRM 76.61 shipping
- RM 118.21RM 64.87 shipping
- RM 118.21RM 64.87 shipping
- RM 120.28RM 76.73 shipping
- RM 118.83RM 98.30 shipping0 bids2d 9h
- RM 74.45RM 75.36 shipping
- RM 49.77Was: RM 62.22was - RM 62.22or Best OfferRM 113.81 shipping
- RM 82.75RM 80.63 shippingOnly 1 left!
- RM 207.34RM 104.15 shipping
- RM 45.58or Best OfferRM 79.30 shipping
- RM 59.06RM 74.91 shipping
- RM 132.68RM 77.06 shipping
- RM 344.26RM 113.44 shipping
- Free ship! Confidence Guaranteed - Pinehurst CoinsRM 132.52RM 77.06 shipping
- RM 143.10RM 107.47 shipping
- RM 124.43Was: RM 165.91was - RM 165.91or Best OfferRM 76.86 shipping
- RM 116.09or Best OfferRM 79.06 shipping
- RM 145.13RM 77.44 shipping
- RM 124.43or Best OfferRM 76.86 shipping
- RM 244.67RM 132.64 shipping
- RM 62.22RM 74.99 shipping
- RM 116.09RM 76.61 shipping
- RM 124.43RM 101.74 shipping
- RM 228.12or Best OfferRM 102.90 shipping
- RM 207.18RM 81.75 shipping
- RM 178.31RM 103.94 shipping
- RM 111.95RM 76.48 shipping
- RM 85.03RM 122.32 shipping
- RM 178.31RM 103.94 shipping
- RM 124.39RM 80.26 shipping
- RM 53.88or Best OfferRM 83.95 shipping
- RM 45.54RM 87.97 shipping
- RM 124.39or Best OfferRM 76.86 shipping
- RM 120.24RM 76.73 shipping
- RM 107.63or Best OfferRM 105.85 shipping
- RM 111.86Was: RM 120.28was - RM 120.28or Best OfferRM 133.10 shipping
- RM 103.65or Best OfferRM 109.42 shipping